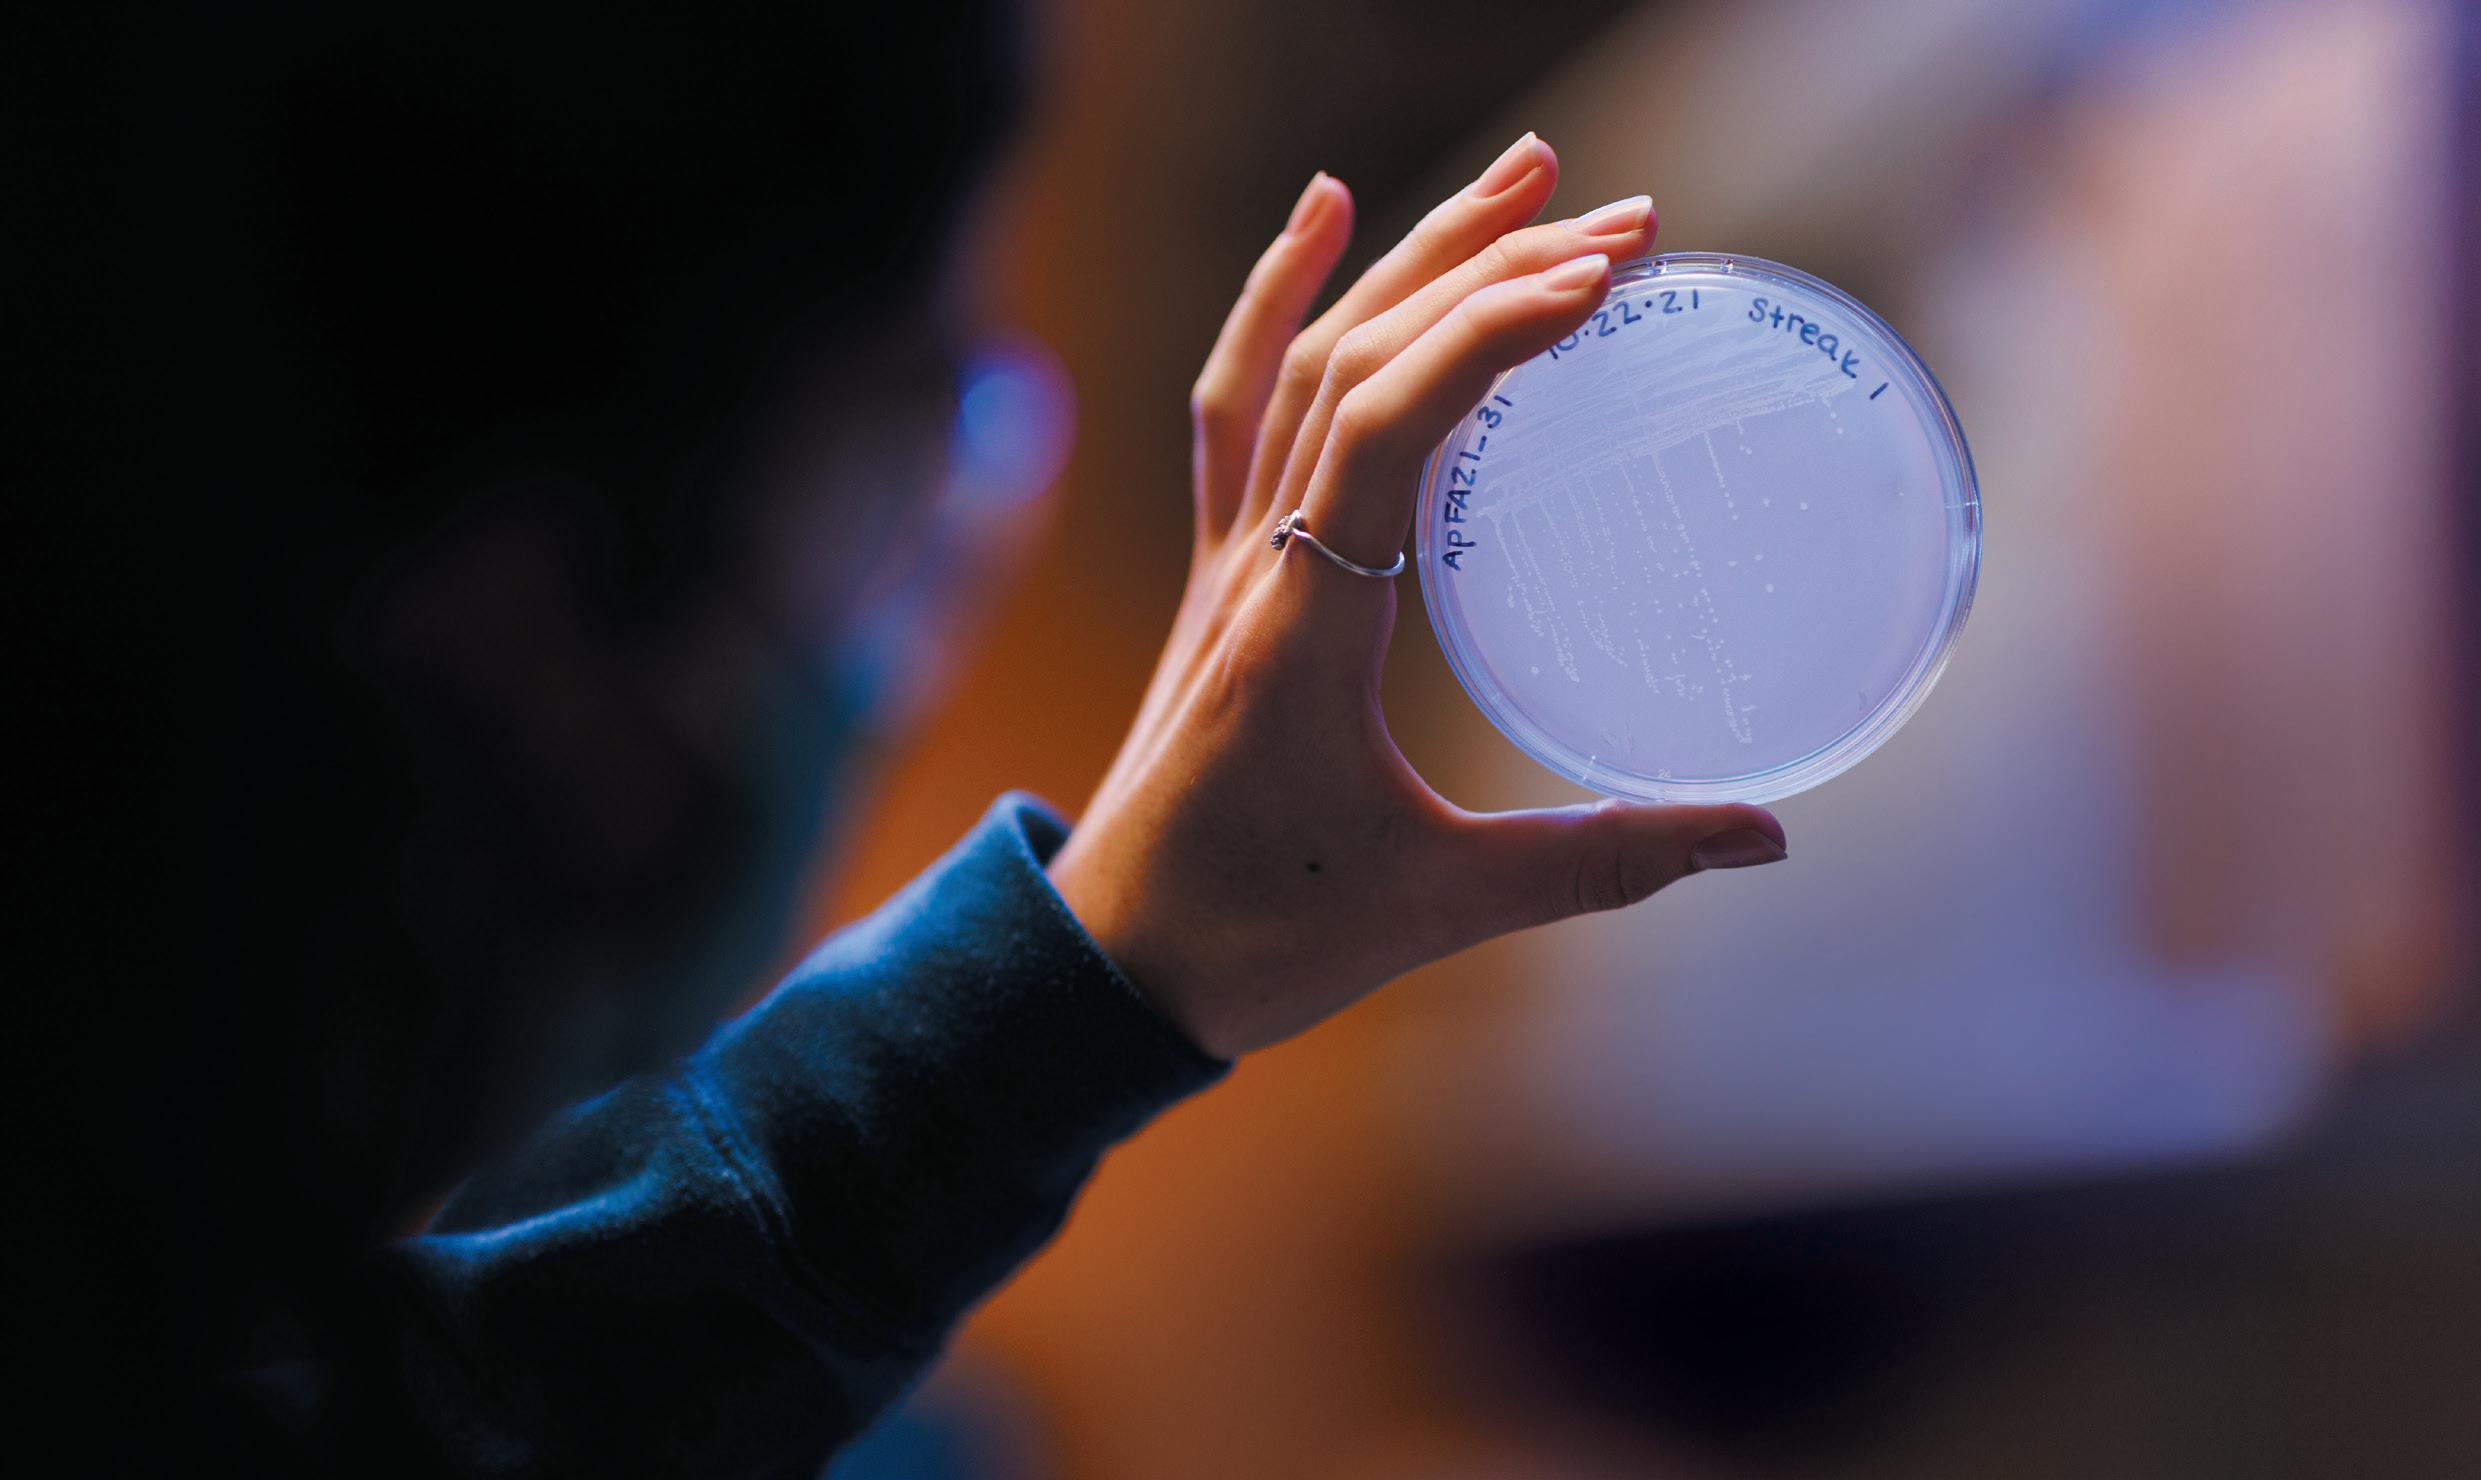

![]()


student-to-faculty ratio

Roger Williams University is a comprehensive university providing over 45 majors and 70-plus minors spanning liberal arts and professional programs. Our students create powerful combinations of degrees, credentials, research and internship opportunities, study-abroad programs, clubs, student organizations, and athletics. When you set foot on our waterfront campus you will connect with students and faculty and feel supported in an environment where you can thrive.
Here are the top ten advantages of choosing RWU.
FIRST-YEAR APPLICANTS KEY DATES
August: Fall application opens
November 15: Early action applications due + Honors Program preferred deadline
February 1: Rolling Regular Decision applications can be submitted any time up until the February 1 due date RWU accepts the Common Application and offers Direct Admission through Niche

TRANSFER APPLICANTS KEY DATES
August: Fall & Spring applications open
November 1: Priority Spring Application Deadline
Rolling admission thereafter
April 1: Priority Fall Application Deadline
Rolling admission thereafter
Employers hire RWU grads because you roll up your sleeves and get involved. Finance students invest and trade multimillion-dollar portfolios, while chemistry majors test new anti-amoebic drug candidates, and art and humanities students display their work in the Bristol community.
Niche.com ranked RWU No. 1 for best college food in Rhode Island, recognizing the quality and range of dining options, commitment to sustainability, and sourcing food locally. Our chefs work to accommodate dietary restrictions and allergies.

80 +
CLUBS AND ORGS
5
From researchers to volunteers, eco-warriors, singers, dancers, and beyond, there is something for everyone within our tight-knit community, from campus events to clubs, groups, and orgs.
Location matters! Bristol is America’s #1 Safest College Town, making it a perfect place to live and explore. Buses can take you to the creative capital city of Providence (home to our second campus) or the famous beaches of Newport. 3



6
Stay healthy your way by playing a varsity sport, taking a fitness class or just taking a walk on our shell path! RWU offers 22 NCAA Division III sports in the Commonwealth

8
Learn abroad for a week, semester, summer, or year. RWU provides opportunities to learn and intern in cities across the U.S. and overseas, with connections in countries like Italy, Chile, Nepal, Bermuda, and the UK.

7
We don’t just say it, we live it. Rhode Island leads in the U.S. as the #1 state for LGBTQ+ safety, and RWU earns high marks on the Campus Pride Index for inclusivity. Engage in multi-faith learning, celebrate First-Gen Day, and build community in our Intercultural Center.

Forge news ways of thinking and working the economy. Make your mark—that’s what Experience builds opportunities for students join research projects and be career-ready
4,560 STUDENTS undergraduate, graduate, and law

22 VARSITY SPORTS plus 8 club sports to meet every interest 96% of graduates are employed or accepted to graduate school within six months of graduation
1 RWU has the only law school in Rhode Island
290 + sustainability-related courses
2 CAMPUSES Bristol and Providence, RI 98% receive financial aid
100% of students complete an RWU Internship Experience

95% of first-year students live on campus
17 affinity and identity groups
We are all about combining programs and taking courses across our eight schools of study. You can pair academic programs with your passions, trailblazing your path. Our expert faculty and staff guide you in selecting your minor or double (or triple!) major.

4
EAT FARM-TO-FORK, EVERY DAY.
Niche.com ranked RWU No. 1 for best college food in Rhode Island, recognizing the quality and range of dining options, commitment to sustainability, and sourcing food locally. Our chefs work to accommodate dietary restrictions and allergies.

Employers hire RWU grads because you roll up your sleeves and get involved. Finance students invest and trade multimillion-dollar portfolios, while chemistry majors test new anti-amoebic drug candidates, and art and humanities students display their work in the Bristol community.
3
KAYAK IN THE A.M., CITY HOP IN THE P.M.
Location matters! Bristol is America’s #1 Safest College Town, making it a perfect place to live and explore. Buses can take you to the creative capital city of Providence (home to our second campus) or the famous beaches of Newport.
80 + CLUBS AND ORGS
5
From researchers to volunteers, eco-warriors, singers, dancers, and beyond, there is something for everyone within our tight-knit community, from campus events to clubs, groups, and orgs.



Stay healthy your way by playing a varsity sport, taking a fitness class or just taking a walk on our shell path! RWU offers 22 NCAA Division III sports in the Commonwealth 6

Learn abroad for a week, semester, summer, or year. RWU provides opportunities to learn and intern in cities across the U.S. and overseas, with connections in countries like Italy, Chile, Nepal, Bermuda, and the UK.

We don’t just say it, we live it. Rhode Island leads in the U.S. as the #1 state for LGBTQ+ safety, and RWU earns high marks on the Campus Pride Index for inclusivity. Engage in multi-faith learning, celebrate First-Gen Day, and build community in our Intercultural Center.

Forge news ways of thinking and working the economy. Make your mark—that’s what Experience builds opportunities for students join research projects and be career-ready


LAND YOUR DREAM JOB.
96% of graduates find employment in companies like NBC, Morgan Stanley, Marvel Entertainment, U.S. Coast Guard, NYU Langone Health, Regeneron, and Thermo Fisher Scientific or acceptance to graduate, law, or medical school within six months of graduation.
CUMMINGS
SCHOOL OF ARCHITECTURE
Architecture
Art & Architectural History
Real Estate*
FEINSTEIN SCHOOL OF HUMANITIES, ARTS & EDUCATION
Academic Exploration Program
Communication and Media Studies
Creative Writing
Dance
Educational Studies
Elementary Education
English Literary Studies
Film Studies*
Food Studies*
Gender and Sexuality Studies*
Graphic Design
History
Journalism
Music
Painting, Drawing and Printmaking*
Photography and Digital Media*
Public Relations
Sculpture and Ceramics*
Secondary Education
Spanish
STEAM Education*
Visual Arts
MARIO J. GABELLI
SCHOOL OF BUSINESS
Accounting
Business*
Business Analytics*
Economics
Entrepreneurship
Finance
International Business
Management
Marketing
Sports Studies*
SCHOOL OF LAW
Juris Doctor Studies in Law, M.S.L.
Everything
SCHOOL OF ENGINEERING, COMPUTING & CONSTRUCTION
MANAGEMENT
Computer Science with specializations in Digital Systems and Customized Program of Study
Construction Management
Engineering with specializations in Civil, Computer, Electrical, Mechanical and Customized Program of Study
SCHOOL OF JUSTICE STUDIES
Criminal Justice
Cybersecurity & Networking
Forensic Science
Legal Studies
Security Assurance Studies
FEINSTEIN SCHOOL OF SOCIAL & NATURAL SCIENCES
Anthropology/Sociology
Applied Mathematics
Aquaculture & Aquarium Science
Biochemistry
Biology
Chemistry
Data Science
Environmental Chemistry
Environmental Science
International Relations
Marine Biology
Mathematics
Physics
Political Science
Psychology
Public Health
Sustainability Studies
MASTER’S PROGRAMS
Architecture, M.Arch
Business Administration, M.B.A.
Criminal Justice, M.S.
Cybersecurity, M.A./M.S.
Forensic Mental Health Counseling, M.A.
Leadership, M.S.
Preservation Practices, M.S.
Public Administration, M.P.A.
Real Estate, M.S.
Special Education, M.A.

ACCELERATED PROGRAMS
Architecture 4+2 B.S./M.Arch.
Biochemistry/Pharmacy 3+4 B.S./Pharm.D.†
Biology/Biotechnology 4+1 B.S./M.S. Biology/Pharmacy 3+4 B.S./Pharm.D.†
Business Administration 3+1 B.S./M.B.A.
Business Administration 4+1 B.S./M.B.A.
Business Law 3+3 B.S./J.D.
Chemistry/Pharmacy 3+4 B.S./Pharm.D.†
Criminal Justice 4+1 B.S./M.S.
Legal Studies 3+3 B.S./J.D.
Preservation Studies 4+1 B.S./M.S.
Real Estate One-Year M.S.
Special Education 4+1 B.S./M.A. †programs offered through an external partnership
PRE-PROFESSIONAL ADVISING TRACKS
Pre-Dentistry
Pre-Law
Pre-Medical Lab Science
Pre-Medicine
Pre-Nursing
Pre-Occupational Therapy
Pre-Pharmacy
Pre-Physical Therapy
Pre-Physician Assistant
Pre-Veterinary Medicine
Pre-Health Professions, General
GRADUATE CERTIFICATES
Cloud Computing
Construction Management
Cyberspecialist
Digital Forensics
Middle School Certification
Public Management
Real Estate
Urban and Regional Planning
Listings with * after are some of our popular minors.
Please note: Almost all majors can also be a minor.